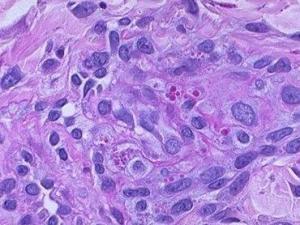

网状肉瘤
病理简介
 (1)肉眼所见:肿瘤多发生于骨干部,从骨干中央向干骺端蔓延,自骨肉向外破坏,肿瘤呈结节状,质地柔软,无包膜。切面呈灰白色,部分区域因出血或坏死而呈暗红色或棕色。肿瘤坏死后,可形成假囊肿,内充满液化的坏死物质。肿瘤破坏骨皮质后,可侵入软组织,在骨膜及其周围形成“洋葱皮”样成层的骨膜增生,此为X线典型表现的基础。
(1)肉眼所见:肿瘤多发生于骨干部,从骨干中央向干骺端蔓延,自骨肉向外破坏,肿瘤呈结节状,质地柔软,无包膜。切面呈灰白色,部分区域因出血或坏死而呈暗红色或棕色。肿瘤坏死后,可形成假囊肿,内充满液化的坏死物质。肿瘤破坏骨皮质后,可侵入软组织,在骨膜及其周围形成“洋葱皮”样成层的骨膜增生,此为X线典型表现的基础。
(2)镜下变化:瘤细胞呈圆形或多角形,形态相当一致,胞浆很少,染色浅,胞膜不清楚。细胞核呈圆形或椭圆形,大小比较一致,颗粒细,分布均匀,核分裂相多见。瘤组织内细胞丰富,细胞排列成巢状,偶见20个左右瘤细胞呈环形排列,形成“假菊形团”结构。瘤组织常有大片坏死。在肿瘤周围可有新骨形成,为反应性新生骨,而不是肿瘤本身成分。
发病比率
 文献中关于尤文氏瘤的发病比率,意见不一,有的提出约占骨原发性恶性肿瘤的7-15%,仅次于骨肉瘤及软骨肉瘤。在描述骨网织细胞肉瘤时常常描写为少见,仅为尤文氏瘤的一半。也有的文献指出尤文氏瘤在临床上比较少见,其发病远较骨肉瘤及软骨肉瘤为少。专家认为后一种意见符合国内实际情况。中国国内查见骨肉瘤273例报告,软骨肉瘤58例,骨网织细胞肉瘤28例,而尤文氏瘤仅有5例报告。这些数字虽不能确切表示其真正发病比率,但总可见一斑。说明尤文氏瘤比较少见,较骨肉瘤及软骨肉瘤为少,较骨网织细胞肉瘤也少。在上述的病例中有4例。
文献中关于尤文氏瘤的发病比率,意见不一,有的提出约占骨原发性恶性肿瘤的7-15%,仅次于骨肉瘤及软骨肉瘤。在描述骨网织细胞肉瘤时常常描写为少见,仅为尤文氏瘤的一半。也有的文献指出尤文氏瘤在临床上比较少见,其发病远较骨肉瘤及软骨肉瘤为少。专家认为后一种意见符合国内实际情况。中国国内查见骨肉瘤273例报告,软骨肉瘤58例,骨网织细胞肉瘤28例,而尤文氏瘤仅有5例报告。这些数字虽不能确切表示其真正发病比率,但总可见一斑。说明尤文氏瘤比较少见,较骨肉瘤及软骨肉瘤为少,较骨网织细胞肉瘤也少。在上述的病例中有4例。
年龄:多局限在5岁以上,30岁以下,以10~25岁最多见。Sherman等收集的111例材料,平均年龄15岁,70%病例发生在10~30岁间。幼儿及年长成人均少见。亦有的文献提出95%发生在4-25岁内。中国国内报告的病例为10-24岁间。
性别:男性较女性多见,Sherman的111例为男性77例,女性34例。中国国内查见的5例加本组的4例共9例,为男7例,女2例。
发病部位
 全身骨骼均可发病,但以四肢长骨的骨干为好发部位,以股骨、胫骨及肱骨最多见,少数发生在干骺端及骨骺。一般青少年以长管状骨为最多,20岁以上则以扁骨为多。髂骨亦较多见,Laffe统计髂骨发病占总数的50%,肩胛骨、肋骨、锁骨、跟骨、脊柱及颅骨等均可发病。国内报告的病例加本组的病例共9例,计股骨4例,肩胛骨2例,胫骨、肱骨及下颌骨各一例。
全身骨骼均可发病,但以四肢长骨的骨干为好发部位,以股骨、胫骨及肱骨最多见,少数发生在干骺端及骨骺。一般青少年以长管状骨为最多,20岁以上则以扁骨为多。髂骨亦较多见,Laffe统计髂骨发病占总数的50%,肩胛骨、肋骨、锁骨、跟骨、脊柱及颅骨等均可发病。国内报告的病例加本组的病例共9例,计股骨4例,肩胛骨2例,胫骨、肱骨及下颌骨各一例。
症状体征
1、疼痛是最常见的临床症状。大约有2/3的患者可有间歇性疼痛。疼痛程度不一,初发时不严重,但迅速变为持续性疼痛;根据部位的不同,局部疼痛将随肿瘤的扩散蔓延。如发生于骨盆部位,疼痛可沿下肢放射,影响髋关节活动;若发生于长骨临近关节,则出现跛行、关节僵硬,还伴有关节积液。肿瘤很少合并有病理骨折,位于脊柱。可产生下肢的放射痛、无力和麻木感;
 2、肿块:随疼痛的加剧而出现局部肿块,肿块生长迅速,表面可呈红、肿、热、痛的炎症表现,压痛显著,表面可有静脉怒张,有时肿块在软组织内生长极块,2~3个月内即可逐人头大。发生于髂骨的肿瘤,肿块可伸入盆腔内,可在下腹部或肛诊时触及肿块。
2、肿块:随疼痛的加剧而出现局部肿块,肿块生长迅速,表面可呈红、肿、热、痛的炎症表现,压痛显著,表面可有静脉怒张,有时肿块在软组织内生长极块,2~3个月内即可逐人头大。发生于髂骨的肿瘤,肿块可伸入盆腔内,可在下腹部或肛诊时触及肿块。
3 、全身症状:患者往往伴有全身症状,如体温升高达38~40℃,周身不适,乏力,食欲下降及贫血等。
另外,肿瘤所在部位不同,还可引起其他症状,如位于股骨下端的病变,可影响膝关节功能,并引起关节反复积液;位于肋骨的病变可引起胸腔积液等。
诊断方法
1、年龄、性别、部位:多发生于10~30岁。男性略多。多发生于股骨、胫骨或腓骨、尺骨等处,亦可发生于髂 尤文氏肉瘤X线表现骨、肩胛骨等。
2、主要症状:进行性疼痛并出现肿块。有时体温升高,白细胞增多。
3 、X线检查:尤文氏瘤的X线表现多种多样,依发生部位不同,表现亦不相同。
(1)长骨:Sherman及Soong二氏根据X线表现,组织学及临床三方面资料为依据,选择了111例进行了研究,重点描述了X线表现。该氏将发生于骨干及干骺端的肿瘤均分为中心型及边缘型两种。
a骨干中心型:最多见,为具有典型X线的部位,病变发生于骨干,常为对称性,早期受累的髓腔中心呈小斑点状或斑片状溶骨性破坏区,呈鼠咬状外观,界限不清,没有骨质硬化,此时病变轻微,亦为早期病变表现。随病程进展,病变区溶骨破坏逐渐增多,破坏区明显扩大,并逐渐出现骨膜反应,呈“洋葱皮”样外观。骨干呈梭形膨胀。约有50%病例于病变中部出现垂直的骨针。少数病人亦可形成骨膜三角。如有条件时,应每隔半月观察一次,由病变早期至出现典型表现仅1-2个月的时间。典型表现出现后,如未能及时治疗,则病变仍迅速扩展,沿骨之长轴广泛蔓延,并由内向外迅速溶骨破坏,可达骨干1/3以上,最后可只剩下一层薄的膨胀了的骨膜新生骨包绕着,有时此层薄壳亦可遭到破坏。肿瘤早期即可侵入软组织,形成不清晰的肿块或弥漫性肿胀。
b骨干皮质型:其特征是骨皮质外层有不同程度的破坏,一般范围较小,有时可呈分叶状,而骨皮质内层常保持完整。软组织肿块常很大,与骨之病变不成比例。亦有成层的骨膜增生或放射状骨针形成。此型较中心型少见。
c干骺端中心型:较少见。大部表现与骨干中心型相似,其不同点是,部位不同,在骨破坏的同时亦有骨质硬化现象。
d干骺边缘型:亦较少见。病变偏于干骺端一侧,呈溶骨性破坏,可表现与溶骨性骨肉瘤相似。本组一例肱骨近端以内侧为主由外向内侵入骨髓腔造成广泛骨质破坏,骨皮质大部消失,并发生病理骨折。病变上端有少量片絮状瘤骨,肿瘤周围软组织肿胀明显,酷似骨肉瘤。
 Sherman及Soong报告骨骺也可同时受到侵犯,造成骨质破坏,称为干骺骨骺型。抗章禄(1963)曾报告一例原发于股骨骨骺的尤文氏瘤。
Sherman及Soong报告骨骺也可同时受到侵犯,造成骨质破坏,称为干骺骨骺型。抗章禄(1963)曾报告一例原发于股骨骨骺的尤文氏瘤。
(2)其他骨:
a肋骨:肋骨的病变呈局限性溶崩 性破坏,同时有球形肿块突入胸内。少数病人可有层状骨膜增生。
b骨盆、肩胛骨:呈圆形或椭圆形骨质破坏,可表现为斑片状或泡沫状破坏区,或表现为增生硬化。亦可在破坏灶内出现棉絮状瘤骨,部分病例可有少量钙化斑点。有的可出现层状骨膜反应或有放射状骨针形成。常伴有软组织肿块。
c脊柱:位于脊柱的病变,引起椎体广泛的骨质破坏,常很快累及椎体之全部,较脊柱结核的破坏更为显著,但椎体的破坏常不对称,而引起楔形变,导致脊柱的成角畸形。随着病变的进展,附件或邻近的椎体也常受到破坏。常无骨膜反应。椎间隙多保持正常。位于脊椎的肿瘤可出现椎旁软组织阴影,与结核的寒性脓肿相似。肿瘤邻近腰大肌时,亦可向腰大肌内浸润,形成腰大肌肿胀。
(3)放射治疗后的表现:在两周内给予3000~5000伦后,约一个月,即可见软组织块消退,骨膜新生骨融合,骨内破坏开始修复,通过放射治疗后,骨结构可以恢复正常。
4实验室检查:可有贫血、白细胞增多及血沉加快。血清乳酸脱氢酶活性也可增高白细胞常增高达1~3万。由于大量骨膜新生骨的形成,血清硷性磷酸酶可轻度增高,这对成年人具有很大诊断意义。肿瘤糖元染色阳性,此与骨网织细胞肉瘤的糖元染色阴性不同。亦有的资料提及本一周氏试验阳性对本瘤也有一定诊断价值。
5转移:肿瘤发展很快,早期即可通过血行发生广泛转移,常转移至肺、肝等脏器,却很少转移至局部淋巴结。本瘤有易转移至其他骨明显地侵犯其他骨的倾向,提示其多中心性的起源。
6血管造影:血管造影对于诊断很有价值。90%的病灶内可显示血管增多且扩张。
7 CT及MRI:能较好地判断肿瘤的范围及侵犯软组织的情况。MRI可见瘤体处广泛性骨质破坏,呈软组织肿块影;在T1加权像上呈均匀的长T1信号;在T2加权像上呈很长T2高信号。在CT上显示为源于骨组织的软组织肿块,骨质广泛破坏.
8核素骨扫描:不仅可显示原发病灶的范围,而且还可发现全身其他病灶。
9 诊断性治疗:尤文氏瘤对放射线非常敏感,肿瘤经照射后,症状可显著好转,故临床上常用其放射敏感性来区别于其他疾病。曹来宾报告一例21岁女性,患左肱骨上部尤文氏瘤,给予局部照射,一年后照射区域肿瘤被控制,病变消失,而肱骨下部照射野外肿瘤又明显发展,并出现放射状骨针。因此,曹氏指出,照射范围应大于X线表现区域,应包括全肿瘤区,否则极易复发。由于尤文氏瘤周身症状可有发热、周身不适及乏力,白细胞增多,血沉快;局部有以疼痛为主的红、肿、热、失功能及明显压痛等酷似炎症的症状,每易误诊为骨髓炎,应予特别注意。
鉴别诊断
 主要须与急性化脓性骨髓炎、骨原发性网织细胞肉瘤、神经母细胞瘤骨转移,以及骨肉瘤相鉴别。
主要须与急性化脓性骨髓炎、骨原发性网织细胞肉瘤、神经母细胞瘤骨转移,以及骨肉瘤相鉴别。
⑴急性化脓性骨髓炎:本病发病急,多伴有高热,疼痛较尤文肉瘤剧烈,化脓时常伴有跳痛,夜间痛并不加重,有些病例伴有胸部其他部位感染。早期的X线片上受累骨改变多不明显,以后于髓腔松质骨中出现斑点状稀疏破坏。在骨破坏的同时很快出现骨质增生,多有死骨出现;穿刺检查,在骨髓炎的早期即可有血性液体或脓性液体吸出,细菌培养阳性,而尤文肉瘤则否。进行脱落细胞学检查有助于诊断。骨髓炎对抗炎治疗有明显效果,尤文肉瘤对放疗极敏感。
⑵骨原发性网织细胞肉瘤:多发生于30~40见闻 ,病程长,全身情况尚好,临床症状不重,X线表现为不规则的溶骨性破坏,有时呈溶冰状,无骨膜反应。病理检查,胞核多不规则,具有多形性,网织纤维比较丰富,包绕着瘤细胞。组织化学检查,包浆内无糖原。
⑶神经母细胞瘤骨转移:多见于5岁以下的幼儿,60%来源于腹膜后,25%来源于纵隔,常无明显原发病症状,转移处有疼痛、肿胀,多合并病理性骨折,尿液检查儿茶酚胺升高。X线片上常很难鉴别;病理上成神经细胞瘤的细胞呈梨形,形成真性菊花样;电镜下瘤细胞内有分泌颗粒。
⑷骨肉瘤:临床表现发热较轻微,主要为疼痛,夜间重,肿瘤穿破皮质骨进入软组织,形成的肿块多偏于骨的一旁,内有骨化影,骨反应的大小、形态常不一致,常见Codman三角及放射状骨针改变。病理上瘤细胞不呈假菊花样排列。
治疗方式
由于尤文肉瘤恶性程度高,病程短,转移快,采用单纯的手术、放疗、单药化疗,效果均不很理想,绝大多数患者在2年内死亡,5年生存率不超过10%。采用综合疗法,使局限尤文肉瘤治疗后5年存活率提高到75%以上。
由于尤文肉瘤恶性程度高,病程短,转移快,采用单纯的手术、放疗、单药化疗,效果均不很理想,绝大多数患者在2年内死亡,5年生存率不超过10%。采用综合疗法,使局限尤文肉瘤治疗后5年存活率提高到75%以上。
1.手术治疗以往手术是治疗本病的主要措施,随着放疗、化疗疗效的提高和对其所产生副作用的对策逐渐完善,单纯采用外科手术治疗的患者日趋减少。手术截肢或截除仍是本病治疗手段之一。
手术治疗的原则是完全切除肿瘤,以最大限度的达到有效的局部控制,防治和减少肿瘤的转移。在此基础上,尽可能多地保留肢体功能,提高病人的生活质量。因此手术治疗的作用日趋重要。Pritchard等报道一组肢体尤文肉瘤,手术治疗的47例患者中,5年存活率为44.7%;非手术治疗的61例,5年存活率仅为13.1%。Wilkin总结了13年治疗140例尤文肉瘤的经验,发现用化疗、放疗和手术治疗组患者5年存活率为74%,而非手术治疗的患者5年存活率为27%,提示手术比保守疗法好。这些综合性资料证明了根除性肿瘤切除的疗效较不完全性肿瘤切除为优。因此,只要病人的全身情况许可,应积极考虑原发灶的手术治疗。
临床上常用的手术种类是截肢术或关节离断术、肿瘤局部切除术、瘤段整块切除重建术。为了正确地选择手术方案,术前应对患者进行全面、认真的评价,根据患者的年龄、肿瘤的部位、肿瘤的大小和肿瘤毗邻的重要解剖组织,决定采用何种手术方式。由于术前大多使用疗程不等的化疗,因此还需估价肿瘤对化疗的临床反应程度,这往往需要比较化疗前后原发病灶的X线片,CT扫描或MRI,以确保手术成功。
2.放疗尤文肉瘤对放疗极为敏感,是治疗尤文肉瘤的主要措施。一般给小剂量(3000~4000rad)照射,能使肿瘤迅速缩小,局部疼痛减轻或消失。但单纯放疗远期疗效很差。Larsson(1973)报道64例,其中大部分单用放疗,个别合并手术治疗。5年生存率只有17%。Dahlin(1981)报道133例,Philip(1967)报道39例单纯放疗者,其5年生存率分别为15%和24%;Dant(1982)报道13例单纯以60Co照射,照射野包括整个骨和软组织,照射剂量每周10Gy,总剂量40~50Gy,结果13例中有9例(69.2%)无病生存期3~30个月,中数生存期10.4个月,Fernadez报道40例单纯放疗局部复发率达47.5%。鉴于此,多数学者主张对于尤文肉瘤放射治疗应该采用早、范围广,有时尚需做肺、脑预防性照射,因为尤文肉瘤在髓腔的扩散范围远比X线片所显示的广泛得多。由于近代影像技术的发展,CT、MRI及同位素骨扫描、血管造影数字减影技术广泛应用临床,能清楚地显示肿瘤在髓腔内范围以及软组织内扩散程度。因此一些学者认为,照射范围可包括肿瘤实际应用在内的上下5cm正常组织,以减少射线对正常组织的损伤,尤其是儿童骨干部肿瘤可免除照射引起的骨骺生长抑制。照射剂量大小因肿瘤部位而异原发躯干部肿瘤如骨盆、脊柱照射剂量为50~60Gy。肢体部肿瘤45~60Gy,其中全骨照射30~40Gy和原发肿瘤部位外加照射10~15Gy。每日照射2Gy,每周5次,放疗在5~6周内完成。为减少局部复发,有些学者用60Gy以上高剂量照射。资料显示,高剂量照射并不能减低肿瘤局部复发,相反副作用明显增加,尤其是放疗部位发生第二肉瘤的危险增加。据报道,第二肉瘤以骨肉瘤常见,其次为纤维肉瘤,发生率为1.2%~2.7%。因此要减低肿瘤的局部复发不能单纯增加照射剂量。
3.化疗尤文肉瘤有效的药物有环磷酰胺、阿霉素、更生霉素、长春新碱、卡氮芥等。组成的联合方案也很多,效果较好的为CVD方案(CTX+VCR+DACT+VCDA)、CVDA方案(在CVD方案的基础上加ADM)等。
常用的抗尤文肉瘤的药物剂量为:长春新碱1.5mg/m2,环磷酰胺500~1200mg/m2,阿霉素20~30mg/m2和放线菌素D450μg/m2。现Rosen等报道的四药化疗方案的具体用法;放线菌素D450μg/m2静脉注射,1次/日×5,第15和29天各开始阿霉素20 mg/m2静脉注射,1次/日×3,第43天开始长春新碱1.5 mg/m2静脉注射,1次/周×4和环磷酰胺1200 mg/m2静脉注射,1次/2周×2,3个月为1个疗程,治疗8个疗程。本方案取得了5年存活率75%的较好结果。
综合治疗:综合治疗系指放疗加化疗加手术或不加手术的综合治疗方法。其方法选择有:
⑴放疗加化疗:主要适用于不能施行手术的患者,包括晚期患者,采用中等量或较大剂量的放疗加药物联合化疗。根据患者的具体情况,放疗和化疗可同时开始或先后应用。
⑵手术切除加中等量放疗加化疗:只要能够将肿瘤切除,则应切除加中等量的放疗加多药联合化疗。也有学者主张先进行联合化疗,待肿瘤明显缩小,再施行大块切除,远端再植或用骨移植,以及人工骨、关节修复缺损。术后原肿瘤所在骨放疗3500rad,再加联合化疗。
⑶手术加放疗或化疗:此方法应用比较少,只是对放疗或化疗不能耐受时才采用,且疗效不优于放疗加化疗。
⑷对已播散的尤文肉瘤治疗:只要全身情况允许,在给予支持疗法的同时,对骨原发灶及转移灶给予放疗加联合化疗。
4.中医中药在放疗、化疗的同时,根据患者的具体全身情况应用中医中药辨证施治,扶正祛邪。制定治疗方案。也可取得一定的疗效。
预后介绍
 女性无转移患者较男性无转移患者预后稍好,发病年龄越年轻预后越差。多数学者认为,尤文肉瘤的预后与患者的年龄、性别无密切关系,肿瘤部位是影响预后的一个重要因素。原发位于肢体者较位于骨盆、骶骨等躯干位预后好。就肢体肿瘤而言,位于肢体远侧者较肢体近侧好。据统计,原发躯干部肿瘤患者3年无瘤存活率为53%,原发肢体者3年无存活率为75%。肿瘤位于骨盆者预后最差,5年存活率为21%,而位于其他部位者为46%。肿瘤大小是影响预后的另一个主要因素,凡肿瘤容积小于100ml,3年无瘤存活率为80%,大于100ml者仅为32%;凡化疗能使肿瘤缩小或消失,在组织学上显示好反应者,预后远较反应差者好,3年无瘤存活率分别为79%和31%。据统计,多药联合化疗方案较单药化疗预后好;尤文肉瘤患者在治疗时,有发热、失重、贫血、血清乳酸脱氢酶高于170U,血沉超过33mm/h,白细胞计数明显增高者,提示预后不良。
女性无转移患者较男性无转移患者预后稍好,发病年龄越年轻预后越差。多数学者认为,尤文肉瘤的预后与患者的年龄、性别无密切关系,肿瘤部位是影响预后的一个重要因素。原发位于肢体者较位于骨盆、骶骨等躯干位预后好。就肢体肿瘤而言,位于肢体远侧者较肢体近侧好。据统计,原发躯干部肿瘤患者3年无瘤存活率为53%,原发肢体者3年无存活率为75%。肿瘤位于骨盆者预后最差,5年存活率为21%,而位于其他部位者为46%。肿瘤大小是影响预后的另一个主要因素,凡肿瘤容积小于100ml,3年无瘤存活率为80%,大于100ml者仅为32%;凡化疗能使肿瘤缩小或消失,在组织学上显示好反应者,预后远较反应差者好,3年无瘤存活率分别为79%和31%。据统计,多药联合化疗方案较单药化疗预后好;尤文肉瘤患者在治疗时,有发热、失重、贫血、血清乳酸脱氢酶高于170U,血沉超过33mm/h,白细胞计数明显增高者,提示预后不良。
相关词条
附件列表
词条内容仅供参考,如果您需要解决具体问题
(尤其在法律、医学等领域),建议您咨询相关领域专业人士。

 尤文氏
尤文氏